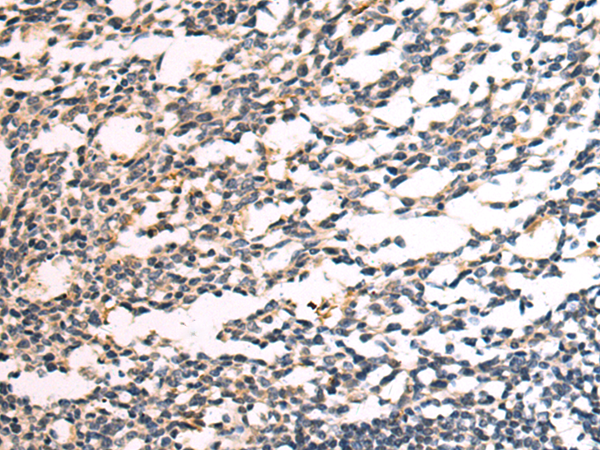

-
分类: 科研抗体货号: P02252别名: Snu23; Ptg-12; hSNU23应用: WB,IHC反应种属: Human, Mouse
-
分类: 科研抗体货号: P02212别名: APT1; LPL1; APT-1; LPL-I; hAPT1应用: WB,IHC反应种属: Human, Mouse, Rat
-
分类: 科研抗体货号: P02224别名: PDCR; SDR17C1应用: WB,IHC反应种属: Human, Mouse, Rat
-
分类: 科研抗体货号: P02251别名: ZF47; Zfp47; ZFP306; ZNF306; ZNF309; zfp-47; ZSCAN13; ZSCAN35; dJ874C20.1; dJ874C20.1应用: IHC反应种属: Human, Mouse
-
分类: 科研抗体货号: P02200别名: TSG应用: WB,IHC反应种属: Human, Mouse, Rat
-
分类: 科研抗体货号: P02223别名: CGI-24; PTD013应用: WB,IHC反应种属: Human, Mouse, Rat
-
分类: 科研抗体货号: P02243别名: MLN50; Lasp-1应用: WB,IHC反应种属: Human, Mouse, Rat
-
分类: 科研抗体货号: P02198别名: CILD18; HEATR2应用: IHC反应种属: Human
-
分类: 科研抗体货号: P02313别名: NA88A; HPX42B; VENTX2应用: IHC反应种属: Human
-
分类: 科研抗体货号: P02240别名: CIS; G18; SOCS; CIS-1; BACTS2应用: IHC反应种属: Human, Mouse, Rat

鄂公网安备42018502007531号
鄂公网安备42018502007531号

